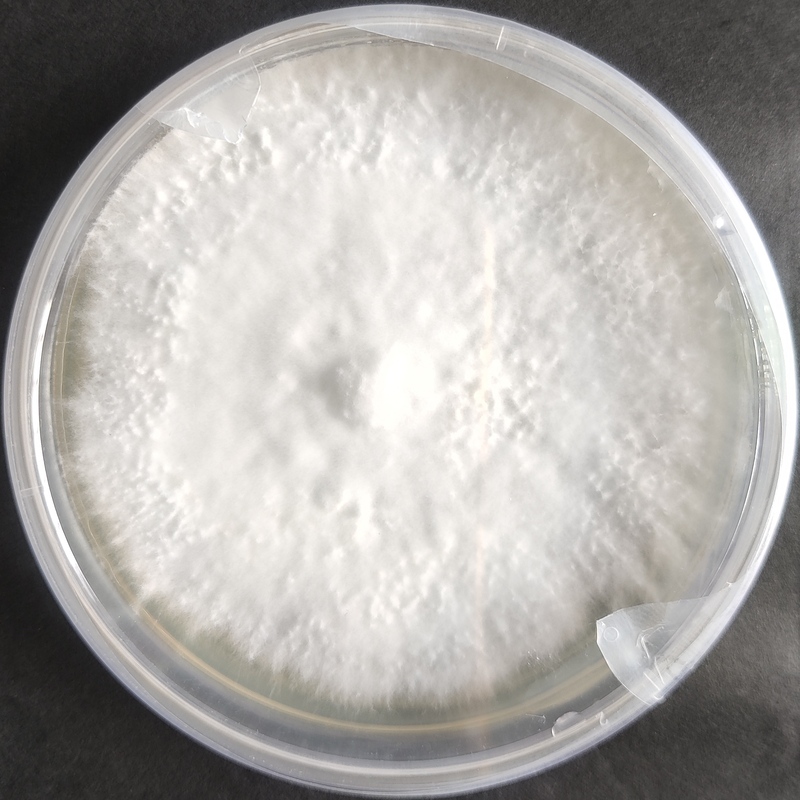

Pleurotus eryngii (King Oyster) – Pure Culture Plate
High-grade Pleurotus eryngii (King Oyster) pure culture plate for reliable spawn production and gourmet cultivation. Known for its thick stem, savory umami flavor, and long shelf life — the preferred choice of chefs and commercial mushroom growers worldwide.
🍄 Proudly prepared and stored at Agripie Agrosystem LLP, India 🇮🇳
The King Oyster Mushroom (Pleurotus eryngii) stands out as the largest and most premium species in the oyster family. It features a thick, meaty stem and small brown cap with a distinct umami flavor and firm texture, making it a favorite in gourmet and medicinal mushroom markets.
Our pure culture plates are aseptically prepared in controlled laboratory conditions to ensure pure, contamination-free, and genetically stable mycelial growth. This strain is carefully maintained for its robust colonization, high fruiting efficiency, and strong disease resistance.
Ideal for:
Commercial mushroom spawn labs and large-scale production units
Gourmet and medicinal mushroom cultivation
Research, strain preservation, and breeding programs
Key Features:
Thick, meaty stem with rich umami taste
Excellent yield and extended shelf life post-harvest
Suitable for temperate to cool climates (15–24°C fruiting range)
Grows well on sawdust, enriched substrates, and supplemented blocks
Premium culinary value for grilling, roasting, and sautéing
Storage & Handling:
Keep refrigerated between 2–8°C. For best results, use within 3–4 weeks of delivery.
🍄 Proudly prepared and stored at Agripie Agrosystem LLP, India 🇮🇳

 |
|  |
| 
